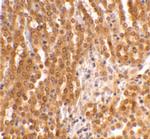
TICAM2 Antibody in Immunohistochemistry (IHC)

Search
Invitrogen
TICAM2 Polyclonal Antibody
{{$productOrderCtrl.translations['antibody.pdp.commerceCard.promotion.promotions']}}
{{$productOrderCtrl.translations['antibody.pdp.commerceCard.promotion.viewpromo']}}
{{$productOrderCtrl.translations['antibody.pdp.commerceCard.promotion.promocode']}}: {{promo.promoCode}} {{promo.promoTitle}} {{promo.promoDescription}}. {{$productOrderCtrl.translations['antibody.pdp.commerceCard.promotion.learnmore']}}
产品信息
PA5-20060
种属反应
宿主/亚型
分类
类型
抗原
偶联物
形式
浓度
规格
纯化类型
保存液
内含物
保存条件
运输条件
RRID
产品详细信息
A suggested positive control is human kidney tissue lysate.
PA5-20060 can be used with blocking peptide PEP-0179.
靶标信息
TRAM, or TRIF-related adaptor molecule (TICAM2), plays an essential role in the MyD88-independent signaling of TLR4. The functional absence of TRAM in vascular endothelial cells restricts TLR4 signaling to MyD88-dependent pathway. Overexpression of TRAM cDNA in endothelial cells reconstituted LPS-induced Trif-dependent NF-kB activation and cxcl10 promoter activity.
仅用于科研。不用于诊断过程。未经明确授权不得转售。
篇参考文献 (0)
生物信息学
蛋白别名: cytoplasmic adaptor; MyD88-4; NF-kappa-B-activating protein 502; Putative NF-kappa-B-activating protein 502; TAG; TICAM-2; TIR domain-containing adapter molecule 2; TIR domain-containing adapter protein; TLR adapter molecule; toll like receptor adaptor molecule 2; Toll-interleukin I receptor domain (TIR)-containing adaptor molecule (TICAM) 2; Toll-like receptor adaptor protein 3; toll/interleukin-1 receptor (TIR) domain-containing adapter protein; Toll/interleukin-1 receptor domain-containing protein; TRIF-related adapter molecule; TRIF-related adapter molecule TRAM; TRIF-related adaptor molecule
基因别名: B430113A10; MyD88-4; TICAM-2; TICAM2; TIRAP3; TIRP; TRAM; Trif
UniProt ID: (Human) Q86XR7, (Mouse) Q8BJQ4
Entrez Gene ID: (Human) 353376, (Mouse) 225471, (Rat) 364867